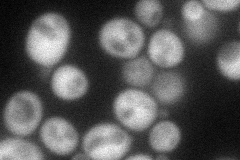
YHR176W
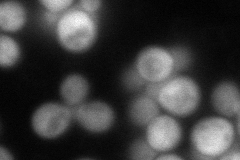
YHR176W
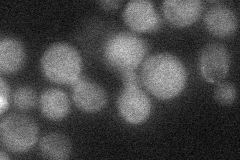
YHR176W
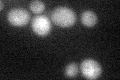
YHR176W

View description
Flavin-containing monooxygenase, localized to the cytoplasmic face of the ER membrane; catalyzes oxidation of biological thiols to maintain the ER redox buffer ratio for correct folding of disulfide-bonded proteins
Localization:
Intensity:
Fold change:
Significance:
-
C’ GFP library in SD

below threshold14.57 -
N' NOP1pr-GFP in SD
cytosol55.7385 -
N' TEF2pr-mCherry in SD
cytosol107.085 -
N' NATIVEpr-GFP in SD
below threshold21.7561 -
N' TEF2pr-VC and Cyto-VN in SD

cytosol48.2428 -
C’ GFP library in SD+DTT
cytosol15.251.04No -
C’ GFP library in SD+H2O2

cytosol15.441.05No -
C’ GFP library in Starvation Media

cytosol17.191.17No -
C’ GFP library on the background of Pup2-DaMP

below threshold -
C’ GFP library on the background of CCT mutant

below threshold15.92661.09256No
